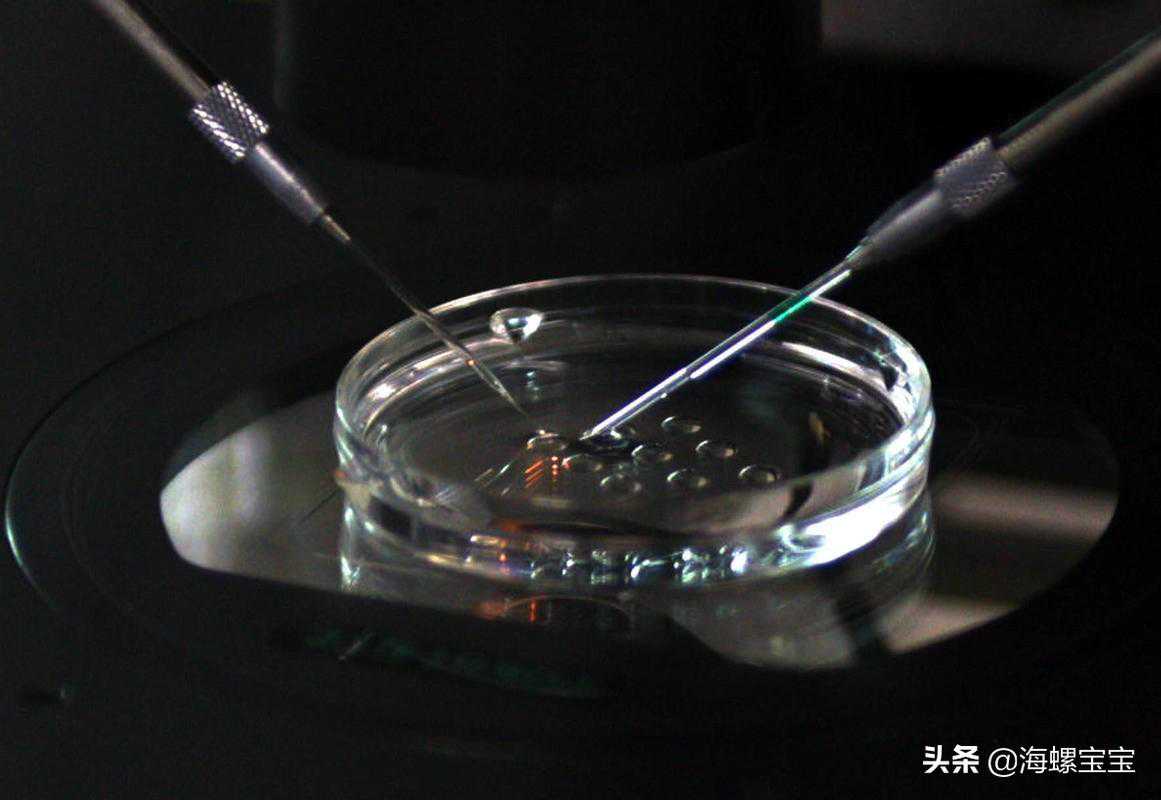

大家好,我来自江西,是一个85后,想和大家分享一下我做试管的整个经历。我结婚比较晚,婚后一年多一直没有怀孕,去医院做了很多检查,打过针吃过药,检查最后得到的结果是说输卵管堵塞,期间来自公公婆婆的压力很大。

一年多期间该看的医生也看了,也在积极治疗还是一直没怀上,最后医生建议去做试管。一开始我是不想做的,因为之后去了解做试管感觉是一件很辛苦的事情。和老公商量了,老公和家里人是同意的,自己考虑了很久,还是决定去做。因为医生说过我这个年纪做试管的成功率比较大,以后年纪越大自然怀孕和做试管的成功率都会更低。

通过一家人到处找人打听最后选定了一个朋友推荐的医院。因为医院不在自己家这边,2017年在老公的陪同下准备好了衣物用品就开车去医院。
到了医院发现人很多,去挂号后等了很久。叫到了我的号之后我就进去和医生说了一下自己的情况,医生听了我的描述说我这个情况做试管的成功率还是挺高的,接着就拿着医生开的单子和老公去做各项检查。

做完检查后医生说要一个星期左右结果才能出来,等所有结果出来了之后再来医院。因为当时有点事耽误了,我们大概过了半个月才去了医院。
去医院的路上两个人都有点紧张,很想早点知道结果。到了医院之后拿到检查结果医生说没什么问题,给我制定了长效长方案,之后打了一针降调,开了宫腔镜进周之前做。

到下一次月经快干净了,老公开车和我一起去医院预约宫腔镜。到医院的时候已经十二点多了,登记预约的医生还没上班。等到两点钟之后医生才来,预约到了第二天做宫腔镜。第二天去了宫腔镜,做完后医生说没什么问题,交代我们一些注意事项之后就回去了。

过了大概一个月我们去医院正式进周促排。由于每天要去医院打针,我们就在医院附近租了一套房子。老公每天陪着我去医院排队打针,打完4、5天左右卵巢的卵泡发育的都挺好,左右卵巢加起来大概有十来个卵泡。期间抽了几次血和做了几次B超,之后按照医生的嘱咐在晚上十二点打了夜针。

第二天就去取了卵,取卵时我打的半麻,取完卵在休息室,医生说总共取了13个卵子。听到医生的话,我和老公都比较开心,心情稍微放松了下来。三天后的下午3点,医生说情况还算挺好,受精成功的胚胎有11个,5个八细胞的胚胎,6个七细胞的胚胎,六细胞的胚胎2个。
之前的过程都还好,之后的移植过程中腹胀很难受,腹胀持续了一个多星期。没有出现腹胀的当天我就拿验孕试纸测了一下,能看到比较明显的水印。当时很高兴,拿着试纸快步走到房间给老公看。大概一个月后去做了B超,医生说宝宝发育的很健康。

在整个孕期,我的饮食都是比较清淡,也会注意营养的均衡,而且难得的是每天保持早睡,九点钟准时上床睡觉。宝宝现在已经一岁多了,很健康,白白胖胖的。有了孩子之后很幸福,这么小的宝宝真的超级可爱,三十多岁的人有了宝宝之后感觉自己都变幼稚了,虽然有时候很难带,但是我们家的幸福感都直线上升了。

感觉自己还是比较幸运的,第一次做试管就成功了,过程也没有像之前在网上查的那么痛苦。希望各位想做试管的姐妹早日成功,有个宝宝真的很幸福呀!



















